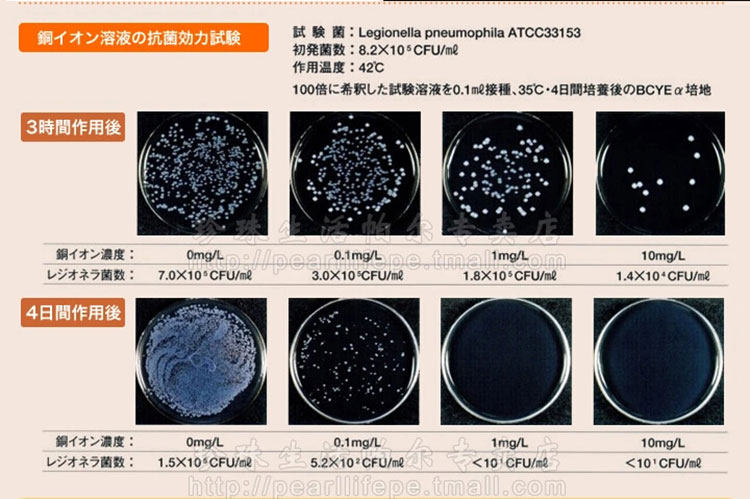

- Таобао
- Еда напиток инструмент
- Чайный сервиз
- Чайники
- 42926212033
Японский оригинальный импортный металлический медный чайник, объем 2

Цена: 56 200руб. (¥2698)
Артикул: 42926212033
Вес товара: ~0.7 кг. Указан усредненный вес, который может отличаться от фактического. Не включен в цену, оплачивается при получении.
Описание товараPHA+PGRpdiBzdHlsZT0ibWFyZ2luOiAwO3BhZGRpbmc6IDA7b3ZlcmZsb3c6IGhpZGRlbjsiPjxpbWcgc3JjPSJodHRwczovL2ltZy5hbGljZG4uY29tL2ltZ2V4dHJhL2k0LzE0MTkyMjIxL1RCMm1SQjhnRlhYWFhiUVhYWFhYWFhYWFhYWC0xNDE5MjIyMS5wbmc/cD13b25iYW9fbWFya2V0aW5nX21lYWxfNzE2NjBfc3RhcnRfdG9wXzEiPjwvZGl2PjxkaXYgZGF0YS10aXRsZT0id29uYmFvX21hcmtldGluZ19tZWFsXzcxNjYwIj48dGFibGUgYWxpZ249ImNlbnRlciIgYmFja2dyb3VuZD0iaHR0cHM6Ly9pbWcuYWxpY2RuLmNvbS9pbWdleHRyYS9pMi80MTQyMjQyODYvVDI3bjdBWHN0YVhYWFhYWFhYLTQxNDIyNDI4Ni5qcGciIGJvcmRlcj0iMCIgY2VsbHBhZGRpbmc9IjAiIGNlbGxzcGFjaW5nPSIwIiBoZWlnaHQ9IjMwOSIgc3R5bGU9ImZvbnQtc2l6ZTogMTIuMHB4O2JhY2tncm91bmQtY29sb3I6ICNmZmZmZmY7YmFja2dyb3VuZC1yZXBlYXQ6IG5vLXJlcGVhdDsiIHdpZHRoPSI3NTAiPjx0cj48dGQgYWxpZ249ImNlbnRlciIgaGVpZ2h0PSIyMzAiPjx0YWJsZSBib3JkZXI9IjAiIGNlbGxwYWRkaW5nPSIwIiBjZWxsc3BhY2luZz0iMCIgaGVpZ2h0PSIyMjAiIHN0eWxlPSJtYXJnaW46IDUuMHB4O3ZlcnRpY2FsLWFsaWduOiBtaWRkbGU7IiB3aWR0aD0iMjIwIj48dHI+PHRkIGNvbHNwYW49IjIiIHN0eWxlPSJib3JkZXI6IDEuMHB4IHNvbGlkICNlNGU0ZTQ7IiB2YWxpZ249Im1pZGRsZSI+PGRpdiBzdHlsZT0id2lkdGg6IDIyMC4wcHg7aGVpZ2h0OiAyMjAuMHB4O292ZXJmbG93OiBoaWRkZW47dGV4dC1hbGlnbjogY2VudGVyOyI+PHRhYmxlIGJvcmRlcj0iMCIgY2VsbHBhZGRpbmc9IjAiIGNlbGxzcGFjaW5nPSIwIj48dHI+PHRkIGFsaWduPSJjZW50ZXIiIGhlaWdodD0iMjIwIiB2YWxpZ249Im1pZGRsZSIgd2lkdGg9IjIyMCI+PGEgaHJlZj0iaHR0cDovL2l0ZW0udGFvYmFvLmNvbS9pdGVtLmh0bT9pZD00MjE0ODcyMDgzMCIgdGFyZ2V0PSJfYmxhbmsiPjxpbWcgYm9yZGVyPSIwIiBoZWlnaHQ9IjIyMCIgc3JjPSJodHRwczovL2ltZy5hbGljZG4uY29tL2Jhby91cGxvYWRlZC9pMS8yMzAwOTM2MDM3L1RCMjdhbEpiZ1JrcHVGankxemVYWGMuNkZYYV8hITIzMDA5MzYwMzcuanBnXzIyMHgyMjAuanBnIiB3aWR0aD0iMjIwIj48L2E+PC90ZD48L3RyPjwvdGFibGU+PC9kaXY+PC90ZD48L3RyPjx0cj48dGQgYWxpZ249ImNlbnRlciIgY29sc3Bhbj0iMiIgc3R5bGU9InBhZGRpbmctYm90dG9tOiA1LjBweDsiIHZhbGlnbj0ibWlkZGxlIiB3aWR0aD0iMTYwIj48ZGl2IHN0eWxlPSJoZWlnaHQ6IDIwLjBweDtsaW5lLWhlaWdodDogMjAuMHB4O292ZXJmbG93OiBoaWRkZW47cGFkZGluZzogMCA1LjBweDtmb250LXNpemU6IDE0LjBweDsiPjxhIGhyZWY9Imh0dHA6Ly9pdGVtLnRhb2Jhby5jb20vaXRlbS5odG0/aWQ9NDIxNDg3MjA4MzAiIHN0eWxlPSJ0ZXh0LWRlY29yYXRpb246IG5vbmU7Y29sb3I6ICM2NjY2NjY7bGluZS1oZWlnaHQ6IDI1LjBweDtmb250LWZhbWlseTog5b6u6L2v6ZuF6buROyIgdGFyZ2V0PSJfYmxhbmsiPlBlYXJsIExpZmUgMzAg0YHQvCDQsdC10Lcg0L/QvtC60YDRi9GC0LjRjywg0L3QtdC20LjRgtCw0Y8g0Y3Qu9C10LrRgtGA0L7QvNCw0LPQvdC40YLQvdCw0Y8g0L/Qu9C40YLQsCDQs9Cw0LfQvtCy0LDRjyDQv9C70LjRgtCwINC40LzQv9C+0YDRgtC40YDQvtCy0LDQvdC90YvQuSDQttC10LvQtdC30L3Ri9C5INCz0L7RgNGI0L7Quiwg0Y/Qv9C+0L3RgdC60LjQuSDQuNC80L/QvtGA0YLQvdGL0Lkg0LLQvtC6PC9hPjwvZGl2PjwvdGQ+PC90cj48dHI+PHRkIGFsaWduPSJsZWZ0IiBzdHlsZT0icGFkZGluZy1sZWZ0OiA1LjBweDtjb2xvcjogIzk5OTk5OTtmb250LXNpemU6IDE0LjBweDtmb250LWZhbWlseTog5b6u6L2v6ZuF6buROyIgd2lkdGg9IjEwMCI+0YbQtdC90LA6PHNwYW4gc3R5bGU9ImNvbG9yOiAjZjQ3YTg5O2ZvbnQtd2VpZ2h0OiBib2xkOyI+77+lIDc2ODwvc3Bhbj48L3RkPjx0ZCBhbGlnbj0ibGVmdCIgYmFja2dyb3VuZD0iaHR0cHM6Ly9pbWcuYWxpY2RuLmNvbS9pbWdleHRyYS9pMS80MTQyMjQyODYvVDJORC5BWHBCYVhYWFhYWFhYLTQxNDIyNDI4Ni5qcGciIGhlaWdodD0iMjMiIHN0eWxlPSJiYWNrZ3JvdW5kLXBvc2l0aW9uOiAwIC0zNjkuMHB4O2JhY2tncm91bmQtcmVwZWF0OiBuby1yZXBlYXQ7IiB3aWR0aD0iNjIiPiZhbXA7bmJzcDs8L3RkPjwvdHI+PC90YWJsZT48L3RkPjx0ZCBhbGlnbj0iY2VudGVyIiBoZWlnaHQ9IjMwOSIgdmFsaWduPSJ0b3AiPjx0YWJsZSBib3JkZXI9IjAiIGNlbGxwYWRkaW5nPSIwIiBjZWxsc3BhY2luZz0iMCIgaGVpZ2h0PSIzMDkiPjx0cj48dGQgYWxpZ249ImNlbnRlciIgdmFsaWduPSJtaWRkbGUiPjx0YWJsZSBib3JkZXI9IjAiIGNlbGxwYWRkaW5nPSIwIiBjZWxsc3BhY2luZz0iMCI+PHRyPjx0ZCBhbGlnbj0iY2VudGVyIiBiYWNrZ3JvdW5kPSJodHRwczovL2ltZy5hbGljZG4uY29tL2ltZ2V4dHJhL2kxLzQxNDIyNDI4Ni9UMk5ELkFYcEJhWFhYWFhYWFgtNDE0MjI0Mjg2LmpwZyIgaGVpZ2h0PSIyMiIgc3R5bGU9ImJhY2tncm91bmQtcmVwZWF0OiBuby1yZXBlYXQ7YmFja2dyb3VuZC1wb3NpdGlvbjogLTE5Mi4wcHggLTM3OC4wcHg7IiB2YWxpZ249Im1pZGRsZSIgd2lkdGg9IjIyIj4mYW1wO25ic3A7PC90ZD48L3RyPjwvdGFibGU+PC90ZD48L3RyPjx0cj48dGQgYWxpZ249ImNlbnRlciIgdmFsaWduPSJtaWRkbGUiPjx0YWJsZSBib3JkZXI9IjAiIGNlbGxwYWRkaW5nPSIwIiBjZWxsc3BhY2luZz0iMCI+PHRyPjx0ZCBhbGlnbj0iY2VudGVyIiBiYWNrZ3JvdW5kPSJodHRwczovL2ltZy5hbGljZG4uY29tL2ltZ2V4dHJhL2kxLzQxNDIyNDI4Ni9UMk5ELkFYcEJhWFhYWFhYWFgtNDE0MjI0Mjg2LmpwZyIgaGVpZ2h0PSIyMiIgc3R5bGU9ImJhY2tncm91bmQtcmVwZWF0OiBuby1yZXBlYXQ7YmFja2dyb3VuZC1wb3NpdGlvbjogLTE5Mi4wcHggLTM3OC4wcHg7IiB2YWxpZ249Im1pZGRsZSIgd2lkdGg9IjIyIj4mYW1wO25ic3A7PC90ZD48L3RyPjwvdGFibGU+PC90ZD48L3RyPjwvdGFibGU+PC90ZD48dGQgYWxpZ249ImNlbnRlciIgaGVpZ2h0PSIzMDkiPjx0YWJsZSBib3JkZXI9IjAiIGNlbGxwYWRkaW5nPSIwIiBjZWxsc3BhY2luZz0iMCIgaGVpZ2h0PSIzMDkiIHN0eWxlPSJ2ZXJ0aWNhbC1hbGlnbjogbWlkZGxlOyI+PHRyPjx0ZD48ZGl2IHN0eWxlPSJ3aWR0aDogMTAwLjBweDtoZWlnaHQ6IDEwMC4wcHg7b3ZlcmZsb3c6IGhpZGRlbjt0ZXh0LWFsaWduOiBjZW50ZXI7Ym9yZGVyOiAxLjBweCBzb2xpZCAjZTRlNGU0OyI+PHRhYmxlIGJvcmRlcj0iMCIgY2VsbHBhZGRpbmc9IjAiIGNlbGxzcGFjaW5nPSIwIj48dHI+PHRkIGFsaWduPSJjZW50ZXIiIGhlaWdodD0iMTAwIiB2YWxpZ249Im1pZGRsZSIgd2lkdGg9IjEwMCI+PGEgaHJlZj0iaHR0cDovL2l0ZW0udGFvYmFvLmNvbS9pdGVtLmh0bT9pZD01MzUzOTczOTQ5NzIiIHRhcmdldD0iX2JsYW5rIj48aW1nIGJvcmRlcj0iMCIgaGVpZ2h0PSIxMDAiIHNyYz0iaHR0cHM6Ly9pbWcuYWxpY2RuLmNvbS9iYW8vdXBsb2FkZWQvaTIvMjMwMDkzNjAzNy9UQjJUdGxmc0ZYWFhYWE9YcFhYWFhYWFhYWFhfISEyMzAwOTM2MDM3LmpwZ18yMjB4MjIwLmpwZyIgd2lkdGg9IjEwMCI+PC9hPjwvdGQ+PC90cj48L3RhYmxlPjwvZGl2PjwvdGQ+PHRkIGFsaWduPSJjZW50ZXIiIGhlaWdodD0iMTAwIiBzdHlsZT0icGFkZGluZy1sZWZ0OiA1LjBweDsiIHZhbGlnbj0ibWlkZGxlIiB3aWR0aD0iMTAwIj48dGFibGUgYm9yZGVyPSIwIiBjZWxscGFkZGluZz0iMCIgY2VsbHNwYWNpbmc9IjAiIGhlaWdodD0iMTAwIiB3aWR0aD0iMTAwIj48dHI+PHRkPjxkaXYgc3R5bGU9ImhlaWdodDogNDQuMHB4O2xpbmUtaGVpZ2h0OiAyMS4wcHg7b3ZlcmZsb3c6IGhpZGRlbjtmb250LXNpemU6IDEzLjBweDsiPjxhIGhyZWY9Imh0dHA6Ly9pdGVtLnRhb2Jhby5jb20vaXRlbS5odG0/aWQ9NTM1Mzk3Mzk0OTcyIiBzdHlsZT0idGV4dC1kZWNvcmF0aW9uOiBub25lOyIgdGFyZ2V0PSJfYmxhbmsiPjxzcGFuIHN0eWxlPSJjb2xvcjogIzY2NjY2Njtmb250LWZhbWlseTog5b6u6L2v6ZuF6buROyI+0K/Qv9C+0L3RgdC60LjQtSDQsdC70Y7QtNCwINGBINC20LDRgNC10L3Ri9C8INGI0L/QsNGC0YzQtdC8LCDQttCw0YDQtdC90YvQtSDQvdCwINC20LDRgNC10L3Ri9GFINGI0L/QsNGC0LXQu9GP0YUsINC60YPRhdC+0L3QvdCw0Y8g0L/QvtGB0YPQtNCwINC40Lcg0YfQuNGB0YLQvtCz0L4g0LbQtdC70LXQt9CwIEgtMzc3IEgtMzc2PC9zcGFuPjwvYT48L2Rpdj48L3RkPjwvdHI+PHRyPjx0ZCBhbGlnbj0ibGVmdCIgc3R5bGU9ImNvbG9yOiAjOTk5OTk5O2hlaWdodDogMjUuMHB4O2xpbmUtaGVpZ2h0OiAxNS4wcHg7Zm9udC1zaXplOiAxMy4wcHg7Ij48c3BhbiBzdHlsZT0iY29sb3I6ICNmNDdhODk7Zm9udC13ZWlnaHQ6IGJvbGQ7Ij7vv6UgMTc4PC9zcGFuPjwvdGQ+PC90cj48dHI+PHRkIGFsaWduPSJsZWZ0IiBiYWNrZ3JvdW5kPSJodHRwczovL2ltZy5hbGljZG4uY29tL2ltZ2V4dHJhL2kxLzQxNDIyNDI4Ni9UMk5ELkFYcEJhWFhYWFhYWFgtNDE0MjI0Mjg2LmpwZyIgaGVpZ2h0PSIyMyIgc3R5bGU9ImJhY2tncm91bmQtcG9zaXRpb246IDAgLTM2OS4wcHg7YmFja2dyb3VuZC1yZXBlYXQ6IG5vLXJlcGVhdDsiIHdpZHRoPSI2MiI+JmFtcDtuYnNwOzwvdGQ+PC90cj48L3RhYmxlPjwvdGQ+PC90cj48dHI+PHRkPjxkaXYgc3R5bGU9IndpZHRoOiAxMDAuMHB4O2hlaWdodDogMTAwLjBweDtvdmVyZmxvdzogaGlkZGVuO3RleHQtYWxpZ246IGNlbnRlcjtib3JkZXI6IDEuMHB4IHNvbGlkICNlNGU0ZTQ7Ij48dGFibGUgYm9yZGVyPSIwIiBjZWxscGFkZGluZz0iMCIgY2VsbHNwYWNpbmc9IjAiPjx0cj48dGQgYWxpZ249ImNlbnRlciIgaGVpZ2h0PSIxMDAiIHZhbGlnbj0ibWlkZGxlIiB3aWR0aD0iMTAwIj48YSBocmVmPSJodHRwOi8vaXRlbS50YW9iYW8uY29tL2l0ZW0uaHRtP2lkPTQzNjYzOTkzNDMwIiB0YXJnZXQ9Il9ibGFuayI+PGltZyBib3JkZXI9IjAiIGhlaWdodD0iMTAwIiBzcmM9Imh0dHBzOi8vaW1nLmFsaWNkbi5jb20vYmFvL3VwbG9hZGVkL2kxL1QxVnEwWlh0TmFYWFhYWFhYWF8hITAtaXRlbV9waWMuanBnXzIyMHgyMjAuanBnIiB3aWR0aD0iMTAwIj48L2E+PC90ZD48L3RyPjwvdGFibGU+PC9kaXY+PC90ZD48dGQgYWxpZ249ImNlbnRlciIgaGVpZ2h0PSIxMDAiIHN0eWxlPSJwYWRkaW5nLWxlZnQ6IDUuMHB4OyIgdmFsaWduPSJtaWRkbGUiIHdpZHRoPSIxMDAiPjx0YWJsZSBib3JkZXI9IjAiIGNlbGxwYWRkaW5nPSIwIiBjZWxsc3BhY2luZz0iMCIgaGVpZ2h0PSIxMDAiIHdpZHRoPSIxMDAiPjx0cj48dGQ+PGRpdiBzdHlsZT0iaGVpZ2h0OiA0NC4wcHg7bGluZS1oZWlnaHQ6IDIxLjBweDtvdmVyZmxvdzogaGlkZGVuO2ZvbnQtc2l6ZTogMTMuMHB4OyI+PGEgaHJlZj0iaHR0cDovL2l0ZW0udGFvYmFvLmNvbS9pdGVtLmh0bT9pZD00MzY2Mzk5MzQzMCIgc3R5bGU9InRleHQtZGVjb3JhdGlvbjogbm9uZTsiIHRhcmdldD0iX2JsYW5rIj48c3BhbiBzdHlsZT0iY29sb3I6ICM2NjY2NjY7Zm9udC1mYW1pbHk6IOW+rui9r+mbhem7kTsiPlBlYXJsIExpZmUgSmFwYW4gSW1wb3J0ZWQgQWR2YW5jZWQgQXRydW1iZXJzIEdsYXNzIENhYmxlIENhYmxlINGBINC/0LXRgNGB0L/QtdC60YLQuNCy0L3QvtC5INC60YDRi9GI0LrQvtC5IDMwINGB0Lwg0YHQv9C10YbQuNCw0LvRjNC90L4g0LTQu9GPIFdvazwvc3Bhbj48L2E+PC9kaXY+PC90ZD48L3RyPjx0cj48dGQgYWxpZ249ImxlZnQiIHN0eWxlPSJjb2xvcjogIzk5OTk5OTtoZWlnaHQ6IDI1LjBweDtsaW5lLWhlaWdodDogMTUuMHB4O2ZvbnQtc2l6ZTogMTMuMHB4OyI+PHNwYW4gc3R5bGU9ImNvbG9yOiAjZjQ3YTg5O2ZvbnQtd2VpZ2h0OiBib2xkOyI+77+lOTg8L3NwYW4+PC90ZD48L3RyPjx0cj48dGQgYWxpZ249ImxlZnQiIGJhY2tncm91bmQ9Imh0dHBzOi8vaW1nLmFsaWNkbi5jb20vaW1nZXh0cmEvaTEvNDE0MjI0Mjg2L1QyTkQuQVhwQmFYWFhYWFhYWC00MTQyMjQyODYuanBnIiBoZWlnaHQ9IjIzIiBzdHlsZT0iYmFja2dyb3VuZC1wb3NpdGlvbjogMCAtMzY5LjBweDtiYWNrZ3JvdW5kLXJlcGVhdDogbm8tcmVwZWF0OyIgd2lkdGg9IjYyIj4mYW1wO25ic3A7PC90ZD48L3RyPjwvdGFibGU+PC90ZD48L3RyPjwvdGFibGU+PC90ZD48dGQgYWxpZ249ImxlZnQiPjx0YWJsZSBhbGlnbj0ibGVmdCIgYmFja2dyb3VuZD0iaHR0cHM6Ly9pbWcuYWxpY2RuLmNvbS9pbWdleHRyYS9pMS80MTQyMjQyODYvVDJORC5BWHBCYVhYWFhYWFhYLTQxNDIyNDI4Ni5qcGciIGJvcmRlcj0iMCIgY2VsbHBhZGRpbmc9IjAiIGNlbGxzcGFjaW5nPSIwIiBoZWlnaHQ9IjI2OCIgc3R5bGU9ImJhY2tncm91bmQtcmVwZWF0OiBuby1yZXBlYXQ7YmFja2dyb3VuZC1wb3NpdGlvbjogMCAwOyIgd2lkdGg9IjE4NSI+PHRyPjx0ZCBhbGlnbj0iY2VudGVyIj48dGFibGUgYWxpZ249ImNlbnRlciIgYm9yZGVyPSIwIiBjZWxscGFkZGluZz0iMCIgY2VsbHNwYWNpbmc9IjAiIHdpZHRoPSIiPjx0cj48dGQgYWxpZ249ImNlbnRlciI+PHRhYmxlIGJvcmRlcj0iMCIgY2VsbHBhZGRpbmc9IjAiIGNlbGxzcGFjaW5nPSIwIj48dHI+PHRkIGFsaWduPSJjZW50ZXIiIGJhY2tncm91bmQ9Imh0dHBzOi8vaW1nLmFsaWNkbi5jb20vaW1nZXh0cmEvaTEvNDE0MjI0Mjg2L1QyTkQuQVhwQmFYWFhYWFhYWC00MTQyMjQyODYuanBnIiBoZWlnaHQ9IjMzIiBzdHlsZT0iYmFja2dyb3VuZC1wb3NpdGlvbjogMCAtMzMyLjBweDtiYWNrZ3JvdW5kLXJlcGVhdDogbm8tcmVwZWF0OyIgd2lkdGg9IjEzNSI+JmFtcDtuYnNwOzwvdGQ+PC90cj48L3RhYmxlPjwvdGQ+PC90cj48dHI+PHRkIGFsaWduPSJjZW50ZXIiIHN0eWxlPSJjb2xvcjogIzVkYjNiNjtsaW5lLWhlaWdodDogMzAuMHB4O2ZvbnQtc2l6ZTogMTQuMHB4O2JvcmRlci1ib3R0b206IDEuMHB4IGRhc2hlZCAjZjg5MzkzOyIgd2lkdGg9IjE4MCI+PGRpdiBzdHlsZT0iaGVpZ2h0OiAzMC4wcHg7bGluZS1oZWlnaHQ6IDMwLjBweDt3aWR0aDogMTYwLjBweDtvdmVyZmxvdzogaGlkZGVuO3RleHQtYWxpZ246IGNlbnRlcjsiPiZhbXA7bmJzcDs8L2Rpdj48L3RkPjwvdHI+PHRyPjx0ZCBhbGlnbj0iY2VudGVyIiBzdHlsZT0iY29sb3I6ICM0ZjRmNGY7bGluZS1oZWlnaHQ6IDMwLjBweDtmb250LXNpemU6IDEyLjBweDsiPjxzcGFuIHN0eWxlPSJ3aWR0aDogMTUwLjBweDt0ZXh0LWFsaWduOiBsZWZ0O2Rpc3BsYXk6IGJsb2NrO3BhZGRpbmctdG9wOiAxMC4wcHg7Ij7QmNGC0L7Qs9C+0LLQsNGPINGG0LXQvdCwOjxmb250IHN0eWxlPSJmb250LXNpemU6IDIwLjBweDtjb2xvcjogIzFlOTBmZjtmb250LWZhbWlseTogYXJpYWw7Ij7vv6UgMTA0NCwwMDwvZm9udD48L3NwYW4+PC90ZD48L3RyPjx0cj48dGQgYWxpZ249ImNlbnRlciIgc3R5bGU9ImNvbG9yOiAjNTU1NTU1O2xpbmUtaGVpZ2h0OiAzMC4wcHg7Zm9udC1zaXplOiAxNC4wcHg7Ij48c3BhbiBzdHlsZT0id2lkdGg6IDE1MC4wcHg7dGV4dC1hbGlnbjogbGVmdDtkaXNwbGF5OiBibG9jazsiPtCm0LXQvdCwINC/0LDQutC10YLQsDo8Zm9udCBzdHlsZT0iZm9udC1zaXplOiAyMC4wcHg7Y29sb3I6ICNmNDdhODk7Zm9udC1mYW1pbHk6IGFyaWFsOyI+77+lIDkyNjwvZm9udD48L3NwYW4+PC90ZD48L3RyPjx0cj48dGQgYWxpZ249ImNlbnRlciIgc3R5bGU9ImNvbG9yOiAjNTU1NTU1O2xpbmUtaGVpZ2h0OiAzMC4wcHg7Zm9udC1zaXplOiAxNC4wcHg7Ij48c3BhbiBzdHlsZT0id2lkdGg6IDE1MC4wcHg7dGV4dC1hbGlnbjogbGVmdDtkaXNwbGF5OiBibG9jazsiPtGB0L7RhdGA0LDQvdGP0YLRjDo8Zm9udCBzdHlsZT0iZm9udC1zaXplOiAyMC4wcHg7Y29sb3I6ICMzY2IzNzE7Zm9udC1mYW1pbHk6IGFyaWFsOyI+77+lIDExOC4wMDwvZm9udD48L3NwYW4+PC90ZD48L3RyPjx0cj48dGQgYWxpZ249ImNlbnRlciIgYmFja2dyb3VuZD0iaHR0cHM6Ly9pbWcuYWxpY2RuLmNvbS9pbWdleHRyYS9pMS80MTQyMjQyODYvVDJORC5BWHBCYVhYWFhYWFhYLTQxNDIyNDI4Ni5qcGciIGhlaWdodD0iNTgiIHN0eWxlPSJiYWNrZ3JvdW5kLXBvc2l0aW9uOiAwIC0yNzIuMHB4O2JhY2tncm91bmQtcmVwZWF0OiBuby1yZXBlYXQ7IiB3aWR0aD0iMTgzIj4mYW1wO25ic3A7PC90ZD48L3RyPjwvdGFibGU+PC90ZD48L3RyPjwvdGFibGU+PC90ZD48L3RyPjwvdGFibGU+PC9kaXY+PGRpdiBzdHlsZT0ibWFyZ2luOiAwO3BhZGRpbmc6IDA7b3ZlcmZsb3c6IGhpZGRlbjsiPjxpbWcgc3JjPSJodHRwczovL2ltZy5hbGljZG4uY29tL2ltZ2V4dHJhL2k0LzE0MTkyMjIxL1RCMm1SQjhnRlhYWFhiUVhYWFhYWFhYWFhYWC0xNDE5MjIyMS5wbmc/cD13b25iYW9fbWFya2V0aW5nX21lYWxfNzE2NjBfZW5kX3RvcF8xIj48L2Rpdj48cD48aW1nIGFsaWduPSJhYnNtaWRkbGUiIHNyYz0iaHR0cHM6Ly9pbWcuYWxpY2RuLmNvbS9pbWdleHRyYS9pMS8yMzAwOTM2MDM3L1RCMjVsXzJoQzBqcHVGankwRmxYWGMwYnBYYV8hITIzMDA5MzYwMzcuanBnIiBzdHlsZT0ibWF4LXdpZHRoOiA3NTAuMHB4OyI+PC9wPjxwPjxpbWcgYWxpZ249ImFic21pZGRsZSIgc3JjPSJodHRwczovL2ltZy5hbGljZG4uY29tL2ltZ2V4dHJhL2kyLzIzMDA5MzYwMzcvVEIyZVhWQWJwWFhYWGNmWFhYWFhYWFhYWFhYXyEhMjMwMDkzNjAzNy5qcGciPjxpbWcgYWxpZ249ImFic21pZGRsZSIgc3JjPSJodHRwczovL2ltZy5hbGljZG4uY29tL2ltZ2V4dHJhL2kzLzIzMDA5MzYwMzcvVEIyc1FSQWJwWFhYWGI1WFhYWFhYWFhYWFhYXyEhMjMwMDkzNjAzNy5qcGciPjxpbWcgYWxpZ249ImFic21pZGRsZSIgc3JjPSJodHRwczovL2ltZy5hbGljZG4uY29tL2ltZ2V4dHJhL2kyLzIzMDA5MzYwMzcvVEIySWRkQmJwWFhYWGJOWFhYWFhYWFhYWFhYXyEhMjMwMDkzNjAzNy5qcGciPjxpbWcgYWxpZ249ImFic21pZGRsZSIgc3JjPSJodHRwczovL2ltZy5hbGljZG4uY29tL2ltZ2V4dHJhL2k0LzIzMDA5MzYwMzcvVEIyVUZSdmJwWFhYWGJLWHBYWFhYWFhYWFhYXyEhMjMwMDkzNjAzNy5qcGciPjxpbWcgYWxpZ249ImFic21pZGRsZSIgc3JjPSJodHRwczovL2ltZy5hbGljZG4uY29tL2ltZ2V4dHJhL2kzLzIzMDA5MzYwMzcvVEIydWxWQWJwWFhYWGJ1WFhYWFhYWFhYWFhYXyEhMjMwMDkzNjAzNy5qcGciPjxpbWcgYWxpZ249ImFic21pZGRsZSIgc3JjPSJodHRwczovL2ltZy5hbGljZG4uY29tL2ltZ2V4dHJhL2kzLzIzMDA5MzYwMzcvVEIyRk0wQWJwWFhYWGI5WFhYWFhYWFhYWFhYXyEhMjMwMDkzNjAzNy5qcGciPjxpbWcgYWxpZ249ImFic21pZGRsZSIgc3JjPSJodHRwczovL2ltZy5hbGljZG4uY29tL2ltZ2V4dHJhL2k0LzIzMDA5MzYwMzcvVEIyV1FwdmJwWFhYWGFXWHBYWFhYWFhYWFhYXyEhMjMwMDkzNjAzNy5qcGciPjxpbWcgYWxpZ249ImFic21pZGRsZSIgc3JjPSJodHRwczovL2ltZy5hbGljZG4uY29tL2ltZ2V4dHJhL2k0LzIzMDA5MzYwMzcvVEIyRVZsRGJwWFhYWGFfWFhYWFhYWFhYWFhYXyEhMjMwMDkzNjAzNy5qcGciPjxpbWcgYWxpZ249ImFic21pZGRsZSIgc3JjPSJodHRwczovL2ltZy5hbGljZG4uY29tL2ltZ2V4dHJhL2kyLzIzMDA5MzYwMzcvVEIyR0J2WmhCNGxwdUZqeTF6alhYY0FLcFhhXyEhMjMwMDkzNjAzNy5qcGciPjxpbWcgYWxpZ249ImFic21pZGRsZSIgc3JjPSJodHRwczovL2ltZy5hbGljZG4uY29tL2ltZ2V4dHJhL2kzLzIzMDA5MzYwMzcvVEIyZWhWQWJwWFhYWGIwWFhYWFhYWFhYWFhYXyEhMjMwMDkzNjAzNy5qcGciPjxpbWcgYWxpZ249ImFic21pZGRsZSIgc3JjPSJodHRwczovL2ltZy5hbGljZG4uY29tL2ltZ2V4dHJhL2kyLzIzMDA5MzYwMzcvVEIyRnNGRmJwWFhYWGFEWFhYWFhYWFhYWFhYXyEhMjMwMDkzNjAzNy5qcGciPjxpbWcgYWxpZ249ImFic21pZGRsZSIgc3JjPSJodHRwczovL2ltZy5hbGljZG4uY29tL2ltZ2V4dHJhL2kyLzIzMDA5MzYwMzcvVEIyaUdCd2JwWFhYWGF1WHBYWFhYWFhYWFhYXyEhMjMwMDkzNjAzNy5qcGciPjxpbWcgYWxpZ249ImFic21pZGRsZSIgc3JjPSJodHRwczovL2ltZy5hbGljZG4uY29tL2ltZ2V4dHJhL2k0LzIzMDA5MzYwMzcvVEIyMmFCSWJwWFhYWGJsWHBYWFhYWFhYWFhYXyEhMjMwMDkzNjAzNy5qcGciPjxpbWcgYWxpZ249ImFic21pZGRsZSIgc3JjPSJodHRwczovL2ltZy5hbGljZG4uY29tL2ltZ2V4dHJhL2kxLzIzMDA5MzYwMzcvVEIyNzJ0QmJwWFhYWGE2WFhYWFhYWFhYWFhYXyEhMjMwMDkzNjAzNy5qcGciPjxpbWcgYWxpZ249ImFic21pZGRsZSIgc3JjPSJodHRwczovL2ltZy5hbGljZG4uY29tL2ltZ2V4dHJhL2kyLzIzMDA5MzYwMzcvVEIyTXlWeWJwWFhYWGNMWFhYWFhYWFhYWFhYXyEhMjMwMDkzNjAzNy5qcGciPjxpbWcgYWxpZ249ImFic21pZGRsZSIgc3JjPSJodHRwczovL2ltZy5hbGljZG4uY29tL2ltZ2V4dHJhL2kxLzIzMDA5MzYwMzcvVEIySlN6VGFWWFhYWGNtWFhYWFhYWFhYWFhYXyEhMjMwMDkzNjAzNy5qcGciPjxpbWcgYWxpZ249ImFic21pZGRsZSIgc3JjPSJodHRwczovL2ltZy5hbGljZG4uY29tL2ltZ2V4dHJhL2kzLzIzMDA5MzYwMzcvVEIyc1F6U2FWWFhYWGFEWHBYWFhYWFhYWFhYXyEhMjMwMDkzNjAzNy5qcGciPjxpbWcgYWxpZ249ImFic21pZGRsZSIgc3JjPSJodHRwczovL2ltZy5hbGljZG4uY29tL2ltZ2V4dHJhL2kzLzIzMDA5MzYwMzcvVEIyU2N2VWFWWFhYWGNYWFhYWFhYWFhYWFhYXyEhMjMwMDkzNjAzNy5qcGciPjxpbWcgYWxpZ249ImFic21pZGRsZSIgc3JjPSJodHRwczovL2ltZy5hbGljZG4uY29tL2ltZ2V4dHJhL2kzLzIzMDA5MzYwMzcvVEIySXVyUWFWWFhYWFh0WEZYWFhYWFhYWFhYXyEhMjMwMDkzNjAzNy5qcGciPjwvcD48c3BhbiBzdHlsZT0iY29sb3I6IHdoaXRlO2xpbmUtZm9udC1zaXplOiAwLjBweDsiPi18LV8tfC08L3NwYW4+PC9wPg==
Продавец:珍珠生活銀泰直营店
Рейтинг:

Всего отзывов:0
Положительных:0
Добавить в корзину
- Информация о товаре
- Фотографии

|
|
|
| ||||||||||||||||||||||||||||